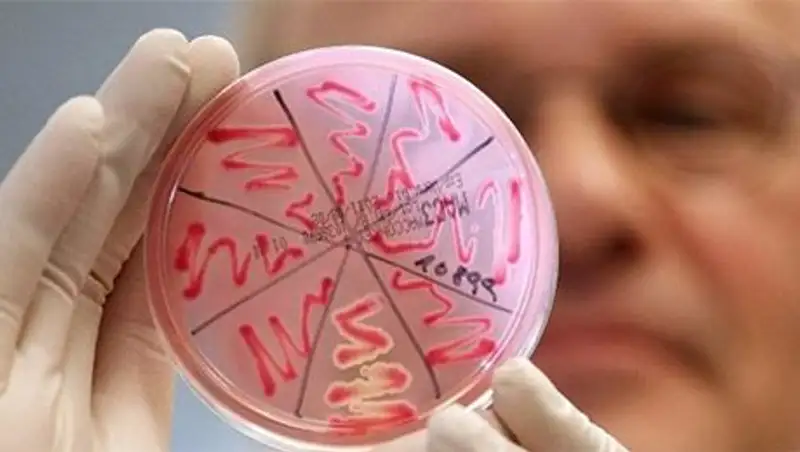
В ЗКО у сельчанки подозревают сибирскую язву

Умерших от сибирской язвы похоронили в гробах с хлорной известью
 Zakon.kz
Zakon.kz
В закрытом на карантин селе идет массовый отлов бродячих животных.
В карагандинском поселке Еркиндык сегодня предали земле тела двух жителей, умерших от сибирской язвы, передает телеканал КТК.
Их захоронили на общем кладбище, но в цинковых гробах. По требованию эпидемиологов, гробы покрыли слоем хлорной извести.
Новых фактов инфицирования, к счастью, больше не выявили. В больнице остаются семеро жителей поселка, в том числе и хозяин заболевшей коровы.
В самом же закрытом на карантин селе шел массовый отлов бродячих животных. Кошки и собаки считаются потенциальными переносчиками инфекции. И чтобы не допустить ее распространения, живность положено уничтожать. Для этого в поселок доставили передвижной крематорий. Специалисты продолжают поэтапную дезинфекцию территории.
Болат Калмаганбетов, и.о. руководителя департамента по защите прав потребителей по Карагандинской области:
- Где было распространено это мясо, вот в 13 очагах, 13 домах проведена заключительная дезинфекция. Это квартира, дом, сарай, санузлы, надворные туалеты и так далее. 92 килограмма постельных принадлежностей и так далее, проведена бескамерная обработка.
Автор: Юлана Чаус
Фото: newskaz.ru
Поделитесь новостью
Читайте также
Если вы видите данное сообщение, значит возникли проблемы с работой системы комментариев. Возможно у вас отключен JavaScript